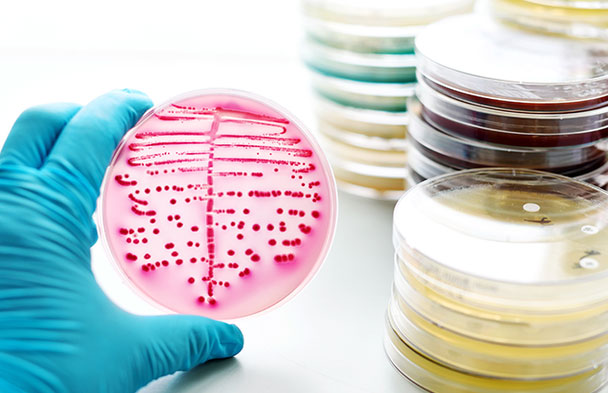
微生物检测常见方法

微生物检测常见方法:
1、琼脂平板培养法
因培养基不同,琼脂平板法分为选择性培养基检测法和显色培养基检测法。选择性培养基是在培养基中加入选择性抑制剂来抑制非目标微生物生长;显色培养基是在培养基中加入细菌特异性酶的显色底物,以菌落颜色区分目的菌落与非目的菌落。
2、显微镜镜检法
将待测样品中的微生物富集后,于油镜下直接计数。显微镜镜检法通常与琼脂平板培养法结合使用,通过琼脂平板培养法对菌落进行定性分析,再用显微镜进行定量计数。传统检测方法虽然对设备要求不高,技术含量也偏低,但耗时长,人工消耗量大,一般检测实验室可根据实际情况合理挑选检测方法,无需拘泥于方法选择的形式。
3、微生物测试片检测技术
一般情况下,微生物测试片由印有网格的聚丙烯薄膜和覆盖有培养基和显色物质的聚乙-烯薄膜组成。待测样品经过处理后可直接接种在微生物测试片上,然后放置在适宜的温度下培养——使固定在测试片上的显色物质与待检微生物生长产生的特异性酶发生显色反应,形成有颜色的菌落,通过对这些菌落进行计数便可实现检测。
测试片法菌落典型,易于判读,且因其操作简便、计数直观,多数可缩短培养周期从而快速得到结果,而且人为操作环节较少,商品化程度高,避免了因人为因素造成误差较大的缺点。
测试片法是蕞为成熟的食源性微生物快速检测方法之一。对于一些热敏感的细菌,由于测试片在整个操作过程中均处于常温环境,可有效避免热损伤,因此能够提供更加精-准的计数结果。测试片可分别检测菌落总数、大肠菌群及大肠杆菌计数、霉菌和酵母计数、肠杆菌科计数、金黄色葡萄球菌和沙门氏菌等,且微生物测试片与传统检测方法之间的相关性非常好,均可达统计学上无显着性差异。目前,因其快速简便的特性,故已广泛应用于我国食品行业和环境、过程及成品的检测。